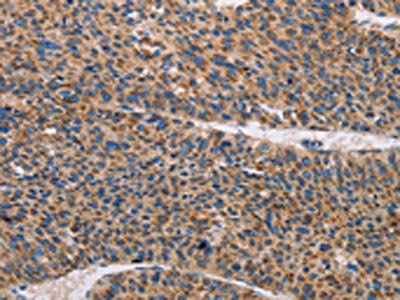

TLR8 Antibody
-
中文名稱:TLR8兔多克隆抗體
-
貨號:CSB-PA289221
-
規格:¥1100
-
圖片:
-
The image on the left is immunohistochemistry of paraffin-embedded Human brain tissue using CSB-PA289221(TLR8 Antibody) at dilution 1/30, on the right is treated with fusion protein. (Original magnification: ×200)
-
The image on the left is immunohistochemistry of paraffin-embedded Human liver cancer tissue using CSB-PA289221(TLR8 Antibody) at dilution 1/30, on the right is treated with fusion protein. (Original magnification: ×200)
-
-
其他:
產品詳情
-
Uniprot No.:
-
基因名:
-
別名:CD 288 antibody; CD288 antibody; CD288 antigen antibody; MGC119599 antibody; MGC119600 antibody; TLR 8 antibody; Tlr8 antibody; TLR8_HUMAN antibody; Toll like receptor 8 antibody; Toll-like receptor 8 antibody
-
宿主:Rabbit
-
反應種屬:Human,Mouse
-
免疫原:Fusion protein of Human TLR8
-
免疫原種屬:Homo sapiens (Human)
-
標記方式:Non-conjugated
-
抗體亞型:IgG
-
純化方式:Antigen affinity purification
-
濃度:It differs from different batches. Please contact us to confirm it.
-
保存緩沖液:-20°C, pH7.4 PBS, 0.05% NaN3, 40% Glycerol
-
產品提供形式:Liquid
-
應用范圍:ELISA,IHC
-
推薦稀釋比:
Application Recommended Dilution ELISA 1:2000-1:5000 IHC 1:50-1:200 -
Protocols:
-
儲存條件:Upon receipt, store at -20°C or -80°C. Avoid repeated freeze.
-
貨期:Basically, we can dispatch the products out in 1-3 working days after receiving your orders. Delivery time maybe differs from different purchasing way or location, please kindly consult your local distributors for specific delivery time.
-
用途:For Research Use Only. Not for use in diagnostic or therapeutic procedures.
相關產品
靶點詳情
-
功能:Endosomal receptor that plays a key role in innate and adaptive immunity. Controls host immune response against pathogens through recognition of RNA degradation products specific to microorganisms that are initially processed by RNASET2. Recognizes GU-rich single-stranded RNA (GU-rich RNA) derived from SARS-CoV-2, SARS-CoV-1 and HIV-1 viruses. Upon binding to agonists, undergoes dimerization that brings TIR domains from the two molecules into direct contact, leading to the recruitment of TIR-containing downstream adapter MYD88 through homotypic interaction. In turn, the Myddosome signaling complex is formed involving IRAK4, IRAK1, TRAF6, TRAF3 leading to activation of downstream transcription factors NF-kappa-B and IRF7 to induce proinflammatory cytokines and interferons, respectively.
-
基因功能參考文獻:
- Conditioned media or microparticles released from obese omental adipose tissue increased CD16 and CCR5 expression on CD14(+)CD16(-) monocytes and augmented their migratory capacity towards the conditioned media from obese omental adipose tissue, itself. PMID: 27677832
- MBZ-induced IL-1beta release was found to be dependent on NLRP3 inflammasome activation and to involve TLR8 stimulation. PMID: 28472897
- the current study shows that motolimod ( selective small-molecule agonist of TLR8, stimulates natural killer (NK) cells, dendritic cells, and monocytes))can be safely administered in combination with cetuximab with an acceptable toxicity profile PMID: 27810904
- Epstein-Barr virus (EBV) replication activating the toll like receptor 8 (TLR8) molecular pathway in primary monocytes. PMID: 28245863
- this study identified TLR8 as mediator of monocyte differentiation and M2 macrophage polarization during hepatitis C virus infection PMID: 28122964
- Demonstrate STAT1-dependent transcriptional activation of TLR8 with estrogen stimulation. PMID: 28039018
- TLR8 gene rs3764880 polymorphisms might be associated with susceptibility to ischemic stroke and involved in the inflammatory reaction and lipid metabolism of ischemic stroke in southern Chinese Han. PMID: 27772795
- this study shows that TLR8 gene polymorphism is associated with susceptibility to HIV and HCV co-infection PMID: 28062211
- Comparison of present and previous association studies reveals contradictory results for common variants. Thus, no associations exist between genetic variation in TLR8 and AR. PMID: 26556310
- Identified human TLR8 as functional TLR13 equivalent that promiscuously senses ssRNA. PMID: 26545385
- TLR8 polymorphisms seem to be related to non-progression of liver fibrosis in HIV/HCV coinfected patients, particularly in males and those patients infected with GT1. PMID: 26455634
- TLR8 with the uncleaved Z-loop is unable to form a dimer. The uncleaved Z-loop located on the ascending lateral face prevents the approach of the dimerization partner by steric hindrance. PMID: 26929371
- Sex-specific associations for TLR8 polymorphisms in tuberculosis. PMID: 26160538
- Knockdown of LRRC59 reduced TLR3-, 8-, and 9-mediated, but not TLR4-mediated, signaling. PMID: 26466955
- the activation of TLR8 by bi-specific si-RNA for the production of INFbeta, was investigated. PMID: 26202481
- Results suggest a relationship between the TLR8 and the susceptibility to Crohn's disease and Behcet's disease. PMID: 26486764
- Carriage of the G-allele of TLR8-rs3764879 was associated with the occurrence of SLE in Danish women, but not men. PMID: 24919757
- TLR8 is identified as receptor for bacterial RNA in primary human monocyte-derived macrophages. Moreover, TLR8-dependent detection of bacterial RNA was critical for triggering monocyte activation in response to infection with Streptococcus pyogenes. PMID: 26101323
- This study demonstrates a physiological role of TLR8 in the sensing of entire S. aureus in human primary phagocytes, including the induction of IFN-beta and IL-12 production via a TAK1-IKKbeta-IRF5 pathway that can be inhibited by TLR2 signaling. PMID: 26085680
- No significant associations have been found between TLR8 polymorphisms and susceptibility to Graves' disease in Chinese Cantonese. PMID: 25430040
- Met1Val of TLR8 is significantly associated with risk of pulmonary tuberculosis susceptibility in southern Punjab population. This effect was highly pronounced among males. PMID: 25572425
- The minor allele of TLR8 rs3764879 of the donor is associated with outcome after myeloablative conditioned allogeneic hematopoietic cell transplantation. PMID: 25464115
- TLR8, but not TLR7, is involved in priming of human neutrophil reactive oxygen species production by inducing the phosphorylation of p47phox and p38 MAPK. PMID: 25877926
- Increased miR-K-10b and miR-K12-12 are functionally involved in sepsis as agonists of TLR8, forming a positive feedback that may lead to cytokine dysregulation. PMID: 25476907
- Data show that activation of toll-like receptor 8 (TLR8) signaling in tumor cells can block the induction and reverse the suppression of senescent naive and tumor-specific T cells in vitro and in vivo, resulting in enhanced anti-tumor immunity. PMID: 25231413
- Data indicate that treatment with toll-like receptor 8 (TLR8) agonists elicited granzyme B production. PMID: 25667415
- TLR8 activation has direct anti-leukemic effects independent of its immunomodulating properties. PMID: 25283842
- The insertion loop between leucine-rich repeats 14 and 15 in TLR8 is indispensable for the receptor cleavage in endosomes. PMID: 25297876
- HIV-1 infection induced the expression of pro-IL-1beta via TLR8-mediated mechanisms and activated caspase-1 through the NLRP3 inflammasome to cleave pro-IL-1beta into bioactive IL-1beta PMID: 24939850
- The mRNA expression level of TLR8 in the patients with cervical cancer and Hela cells were up-regulated, it consistent with the increased expression of VEGF and Bcl-2. PMID: 24782650
- Data indicate 4-methyl-1-pentyl-1H-benzo[d]imidazol-2-amine a pure toll-like receptor 8 (TLR8) agonist, evoking proinflammatory cytokine and Type II interferon responses in mononuclear leukocytes. PMID: 25102141
- non-synonymous TLR8 SNP rs3764880-G allele was a risk factor for oral ulcer and pericardial effusion, with significant additive effects PMID: 24445780
- Variations in TLR8 genes may modulate immune responses during HCV infection. PMID: 24205871
- TLR8 is a novel estrogen target gene that can lower the inflammatory threshold and implicate an IFNalpha-independent inflammatory mechanism that could contribute to higher systemic lupus erythematosus incidence in women. PMID: 24525049
- The mechanisms of action of Aldaratrade mark are complex. Imiquimod is an effective ligand for TLR7 (and TLR8 in humans) and also interferes with adenosine receptor signaling. PMID: 24254490
- Bb RNA is a TLR8 ligand in human monocytes and that transcription of IFN-beta in response to the spirochete is induced from within the phagosomal vacuole through the TLR8-MyD88 pathway. PMID: 23906644
- Data indicate that TLR8 stimulation of NK-DC co-cultures significantly increased DC priming of EGFR-specific CD8(+) T cells in the presence of cetuximab. PMID: 23685782
- TLR8 expression and signaling is impaired in peripheral blood mononuclear cells from patients with multiple sclerosis PMID: 23787171
- This study demonstrates profibrotic properties of circulating monocytes from patients with systemic sclerosis and a key role for TLR signalling, particularly TLR8, in TIMP-1 secretion and matrix remodelling. PMID: 23223421
- crystal structures of unliganded and ligand-induced activated TLR8 dimers were elucidated; ligand binding induces reorganization of the TLR8 dimer, which enables downstream signaling processes PMID: 23520111
- Single nucleotide polymorphism in the TLR8 gene is associated with allergic rhinitis. PMID: 22857391
- IL10 production after TLR9 ligands or HSV-1 stimulation was significantly related with plasma levels of sex hormones, whereas no correlation was found in cytokines produced following TLR7 and TLR8 stimulation. PMID: 22768144
- Expression of TLR8 is significantly increased in HeLa cells. TLR8 agonist may influence tumor development. PMID: 22340042
- UNC93B1 physically associates with human TLR8 and regulates TLR8-mediated signaling PMID: 22164301
- Epigenetic regulation of tumor necrosis factor alpha (TNFalpha) release in human macrophages by HIV-1 single-stranded RNA (ssRNA) is dependent on TLR8 signaling PMID: 22393042
- analyzed the frequency of TLR7 rs179008, TLR8 rs3764880, TLR9 rs5743836 and rs352140 in 370 patients with SLE and 415 healthy controls from southern Brazil PMID: 22065095
- Human TLR8 detectS viral single-stranded RNA and imidazoquinoline compounds. Review. PMID: 22289837
- Quantitative polymerase chain reaction showed significantly higher expression of LEAP-1 (P = 0.002) and TLR-8 (P = 0.023) and TLR-10 (P = 0.014) in viral keratitis and LEAP-2 (P = 0.034) in dry eye, versus controls. PMID: 21499082
- Lower toll-like receptor 8 expression was observed in monocytes from infants with respiratory syncytial virus infection. PMID: 20946625
- Phagosomal signaling involves a cooperative interaction between TLR2 and TLR8 in pro- and antiinflammatory cytokine responses, whereas TLR8 is solely responsible for IRF7-mediated induction of IFN-beta. PMID: 21321205
顯示更多
收起更多
-
亞細胞定位:Endosome membrane; Single-pass type I membrane protein.
-
蛋白家族:Toll-like receptor family
-
組織特異性:Expressed in myeloid dendritic cells, monocytes, and monocyte-derived dendritic cells.
-
數據庫鏈接:
Most popular with customers
-
-
YWHAB Recombinant Monoclonal Antibody
Applications: ELISA, WB, IHC, IF, FC
Species Reactivity: Human, Mouse, Rat
-
Phospho-YAP1 (S127) Recombinant Monoclonal Antibody
Applications: ELISA, WB, IHC
Species Reactivity: Human
-
-
-
-
-